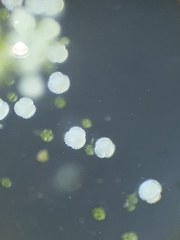
Sphaerocarpos michelii

Sphaerocarpos michelii: taxon details and analytics
- Domain
- Kingdom
- Plantae
- Phylum
- Marchantiophyta
- Class
- Marchantiopsida
- Order
- Sphaerocarpales
- Family
- Sphaerocarpaceae
- Genus
- Sphaerocarpos
- Species
- Sphaerocarpos michelii
- Scientific Name
- Sphaerocarpos michelii
Summary description from Wikipedia:
Gestekeld blaasjesmos
Gestekeld blaasjesmos (Sphaerocarpos michelii) is een levermos behorend tot de familie Sphaerocarpaceae. Het is een tweehuizige winterannuel van akkers, stoppelvelden, bloemenvelden, groentetuinen, campings en dergelijke.
...Sphaerocarpos michelii in languages:
- Dutch
- Gestekeld blaasjesmos
- English
- Micheli's Balloonwort
- German
- Michelis Bläschenmoos
- German
- Michelis Kugelhornmoos
- Polish
- tetrasporowiec Micheliego
Images from inaturalist.org observations:
We recommend you sign up for this excellent, free service.